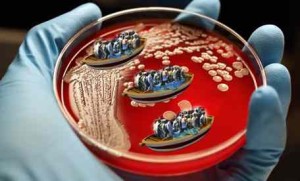

Emergenza globale per epidemie e batteri resistenti ai farmaci
http://vs.ansa.it/sito/video_mp4_export/m20190501140237261.mp4 Inquietante in città degli sbarchi: ha Tubercolosi multiresistente, lo trasportano così – FOTO Allarme TBC resistente ai farmaci: “Nel 90 per cento dei casi in immigrati” Vox Arriva la Super-Scabbia: resistente ai farmaci, non basta la ‘pomata’ Allarme da Società di infettivologia pediatrica: “Servono controlli su immigrati, portano TBC resistente ai farmaci” Segui Vox